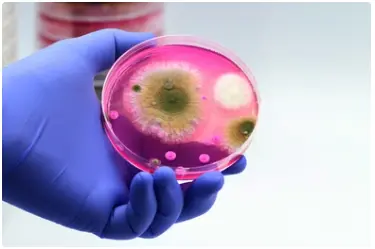

Fungal Tools in Research
Fungi are not only organisms that scientists study, they are also practical tools in many areas of biology.
Their natural properties make them easy to use in laboratories for experiments, teaching, and applied science.
Yeast as a Workhorse
The yeast Saccharomyces cerevisiae is one of the most widely used model organisms in biology. It is simple to grow, fast to reproduce, and its genome is well understood. Scientists use yeast to:
- Test the function of new genes.
- Study how cells divide and respond to stress.
- Produce proteins that can be studied in detail.
Because yeast cells share many features with human cells, they are often used to predict how human biology works.
Fungal Enzymes in the Lab
Laboratories often rely on enzymes produced by fungi. These enzymes help researchers perform specific reactions. Examples include:
DNA-modifying enzymes
used in molecular biology experiments.
Degrading enzymes
to break down plant material for energy studies.
Microscopy and Visualization
Some fungi naturally produce pigments or fluorescent molecules. These properties are used to:
- Track growth under the microscope.
- Highlight interactions between cells.
- Compare normal and stressed cells.
This makes fungi not just subjects of research, but also tools to visualize biological events.